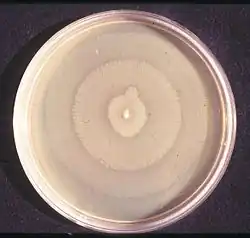

Proteus mirabilis
| Proteus mirabilis | ||||||||||||
|---|---|---|---|---|---|---|---|---|---|---|---|---|
Kolonien von Proteus mirabilis auf XLD-Agar | ||||||||||||
| Systematik | ||||||||||||
| ||||||||||||
| Wissenschaftlicher Name | ||||||||||||
| Proteus mirabilis | ||||||||||||
| Hauser, 1885 |
Proteus mirabilis ist der Name einer gramnegativen Bakterienart, deren Vertreter stäbchenförmig sind und zur Gattung Proteus in der Familie der Morganellaceae gehören.
Mikrobiologische Eigenschaften
Proteus mirabilis sind gramnegative, fakultativ anaerobe, nicht sporenbildende, stark peritrich begeißelte – und damit sich lebhaft bewegende – stäbchenförmige Bakterien.[1] P. mirabilis ist in der Regel ein harmloser Saprophyt (Destruent organischer Stoffe).
Die Bakterien bilden das Enzym Urease, das Harnstoff spalten kann. Dabei entsteht Ammoniak, der den pH-Wert des Mediums, zum Beispiel von Urin, erhöht und dem Bakterium damit bessere Wachstumsbedingungen gewährt (ein niedriger pH-Wert wird von den meisten Bakterien schlecht toleriert). Weitere wichtige Enzyme, über die sie verfügen, sind die Phenylalanin-Desaminase und die Ornithindecarboxylase (ODC). Hingegen fehlen die Enzyme Lysindecarboxylase (LDC) und Arginindihydrolase (ADH). Sie können Schwefelwasserstoff aus schwefelhaltigen Aminosäuren bilden und sind in der Lage, Gelatine zu hydrolysieren. Ihnen fehlt die Fähigkeit, Lactose zu verstoffwechseln. Die fehlende Indol-Produktion fast aller Stämme erlaubt eine einfache Abgrenzung von der zweithäufigsten Art der Gattung, Proteus vulgaris (Indol-Test positiv).[1]
Proteus-Bakterien können problemlos auf gängigen Kulturmedien kultiviert werden. Sie bilden dabei auf Gelmedien oft nicht umschriebene Kolonien wie die meisten anderen Bakterien, sondern können sich flächig auf dem Nährmedium ausbreiten („Schwärm-Phänomen“, siehe Abbildung rechts). Wie schon 1946 bemerkt wurde, können dabei einzelne Kolonien (Schwärme) eine deutlich sichtbaren Abgrenzung zu anderen Kolonien ausbilden, was noch heute zur Klassifizierung dieser Mikroorganismen benutzt wird und unter anderem an verschiedenen (für die jeweils andere Kolonie giftig wirkenden) Proteinen aus der Familie der Proticine liegt.[2]
Die Bakterien sind in ihrer Länge sehr unterschiedlich, dies führte zur Benennung nach dem alten griechischen Meeresgott Proteus, der sich durch große Wandlungsfähigkeit auszeichnete.
Das Genom von Proteus mirabilis wird momentan vom Sanger Institute (Cambridge, Großbritannien) entschlüsselt.
Bedeutung als Krankheitserreger
Bei Proteus mirabilis handelt es sich um einen fakultativ pathogenen (opportunistischen) Krankheitserreger, der auch bei Gesunden häufig im Dickdarm vorkommt und nicht notwendigerweise Krankheiten verursacht. Entsprechend immungeschwächte Personen können unter folgenden, von diesem Bakterium verursachten, Krankheitsbildern leiden: Harnwegsinfekt, Wundinfektion, Pneumonie und Sepsis.
Bei chronischen Harnwegsinfektionen durch Proteus mirabilis kann durch die Erhöhung des Urin-pH-Wertes die Entstehung von Harnsteinen begünstigt werden.
Ausbreitung
Typischerweise kommt es nicht zu einer Übertragung des Erregers von Mensch zu Mensch. Infektionsquelle ist die körpereigene Bakteriengesellschaft des Darms.
Häufigkeit
Proteus mirabilis ist ein seltener Krankheitserreger. Harnwegsinfekte werden in ca. 5–10 % der Fälle durch dieses Bakterium verursacht. Bei Pneumonie und Sepsis bewegt sich der Anteil um 2 %. Diese Zahlen gelten für ambulant erworbene Infektionen, bei nosokomialen Infektionen liegt die Rate tendenziell etwas höher. Selten auftretende Indol-positive Stämme des Bakteriums Proteus mirabilis haben jedoch eine Multiresistenz entwickelt.[3]
Diagnostik
Die Diagnosestellung erfolgt durch Kultivierung des Erregers aus Blut- und Urinkulturen, Bronchialsekret oder Bronchoalveolärer Lavage. Nach Anlegen einer Reinkultur kann die Spezies am einfachsten mit biochemischen Methoden („Bunte Reihe“) bestimmt werden.
Therapie
Die Behandlung einer Infektion durch Proteus mirabilis sollte, wann immer möglich, nach Resistenzprüfung (Antibiogramm) durchgeführt werden. Die anfängliche „kalkulierte“ Therapie kann z. B. mit Cotrimoxazol, einem Cephalosporin der 2./3. Generation[4] oder mit einem Fluorchinolon erfolgen. Natürliche Resistenzen bestehen gegenüber Tetracyclinen, Tigecyclin, Colistin und Nitrofurantoin[5].
Problematisch für die Therapie sind Bakterienstämme, die extended-spectrum-β-Lactamasen (ESBL) produzieren. Solche Bakterienstämme sind gegen Antibiotika vom β-Lactam-Typ (z. B. Penicilline, Cephalosporine aller Generationen) resistent.
Historisches
Proteus mirabilis wurde 1885 von dem Erlanger Pathologen Gustav Hauser entdeckt und erstbeschrieben. Der Artikel trägt den Namen Über Fäulnisbakterien und deren Beziehungen zur Septicämie. Ein Beitrag zur Morphologie der Spaltpilze. Das Epitheton P. mirabilis bedeutet „wundervoll, erstaunlich“.[6]
Die OX-Antigene von Proteus, vor allem OX-19, sind Agglutinine der Weil-Felix-Reaktion, dem klassischen Nachweisverfahren für von Rickettsien ausgelöstes Fleckfieber, da sie eine Kreuzreaktivität mit menschlichen Antikörpern gegen Rickettsien aufweisen und so bei Zugabe zum Blut eine Agglutination („Ausfällung“) verursachen. Der Test hat aber eine geringe Spezifität und Sensitivität. Im Zweiten Weltkrieg gelang es im besetzten Polen den beiden Ärzten Stanisław Matulewicz und Eugeniusz Łazowski, durch eine Injektion mit Proteus-Suspensionen über Jahre eine Fleckfieber-Epidemie vorzutäuschen und so geschätzte 8.000 Menschen zu retten.[7]
Weiterführende Literatur
- Seigo Iwata, Taisei Nishiyama, Matomo Sakari, Yuki Doi, Naoki Takaya, Yusuke Ogitani, Hiroshi Nagano, Keisuke Fukuchi, Eijiro Miyako: Tumour-resident oncolytic bacteria trigger potent anticancer effects through selective intratumoural thrombosis and necrosis. In: Nature Biomedical Engineering, 5. August 2025; doi:10.1038/s41551-025-01459-9 (englisch). Dazu:
- Challenging over 150 years of cancer immunotherapy: AUN bacteria herald an immune-independent breakthrough. Auf: EurekAlert! vom 5. August 2025. Quelle: Japan Advanced Institute of Science and Technology. Gleichlautend:
- Linda Stewart: AUN bacteria herald an immune-independent breakthrough. Auf: The Microbiologist vom 5. August 2025.
Weblinks
Einzelnachweise
- ↑ a b C. M. O'Hara, F. W. Brenner, J. M. Miller: Classification, identification, and clinical significance of Proteus, Providencia, and Morganella. In: Clinical Microbiology Reviews. Band 13, Nr. 4. American Society for Microbiology, Oktober 2000, ISSN 0893-8512, S. 534–546, doi:10.1128/cmr.13.4.534-546.2000, PMID 11023955, PMC 88947 (freier Volltext).
- ↑ Spektrum der Wissenschaft. Januar 2009, S. 16–17: Bakterielle Vereinsmeierei.
- ↑ Empfehlung der Kommission für Kranken-haushygiene und Infektionsprävention (KRINKO) beim Robert Koch-Institut (RKI): Hygienemaßnahmen bei Infektionen oder Besiedlung mit multiresistenten gramnegativen Stäbchen. In: Bundesgesundheitsblatt. 2012, Nr. 55, Oktober 2012, S. 1311–1354, doi:10.1007/s00103-012-1549-5 (Volltext als PDF-Datei), speziell: S. 1318 → 2.1.4 Andere Enterobakterien.
- ↑ "Wirkstoff aktuell: Rationale Antibiotikatherapie bei Harnwegsinfektionen", Ausgabe 2/2012 ( vom 7. November 2014 im Internet Archive)
- ↑ R. Leclercq et al.: EUCAST expert rules in antimicrobial susceptibility testing. In: Clinical Microbiology and Infection. Band 19, Nr. 2. Wiley-Blackwell, 2013, ISSN 1469-0691, S. 141–160, doi:10.1111/j.1469-0691.2011.03703.x, PMID 22117544 (wiley.com [abgerufen am 17. Februar 2013]).
- ↑ Jean Euzéby, Aidan C. Parte: Genus Proteus. In: List of Prokaryotic names with Standing in Nomenclature (LPSN). Abgerufen am 23. Dezember 2019.
- ↑ John D. C. Bennett, Lydia Tyszczuk: Deception by immunisation, revisited British Medical Journal 1990, Band 301, Ausgabe vom 22.–29. Dezember 1990, Seiten 1471–1472
